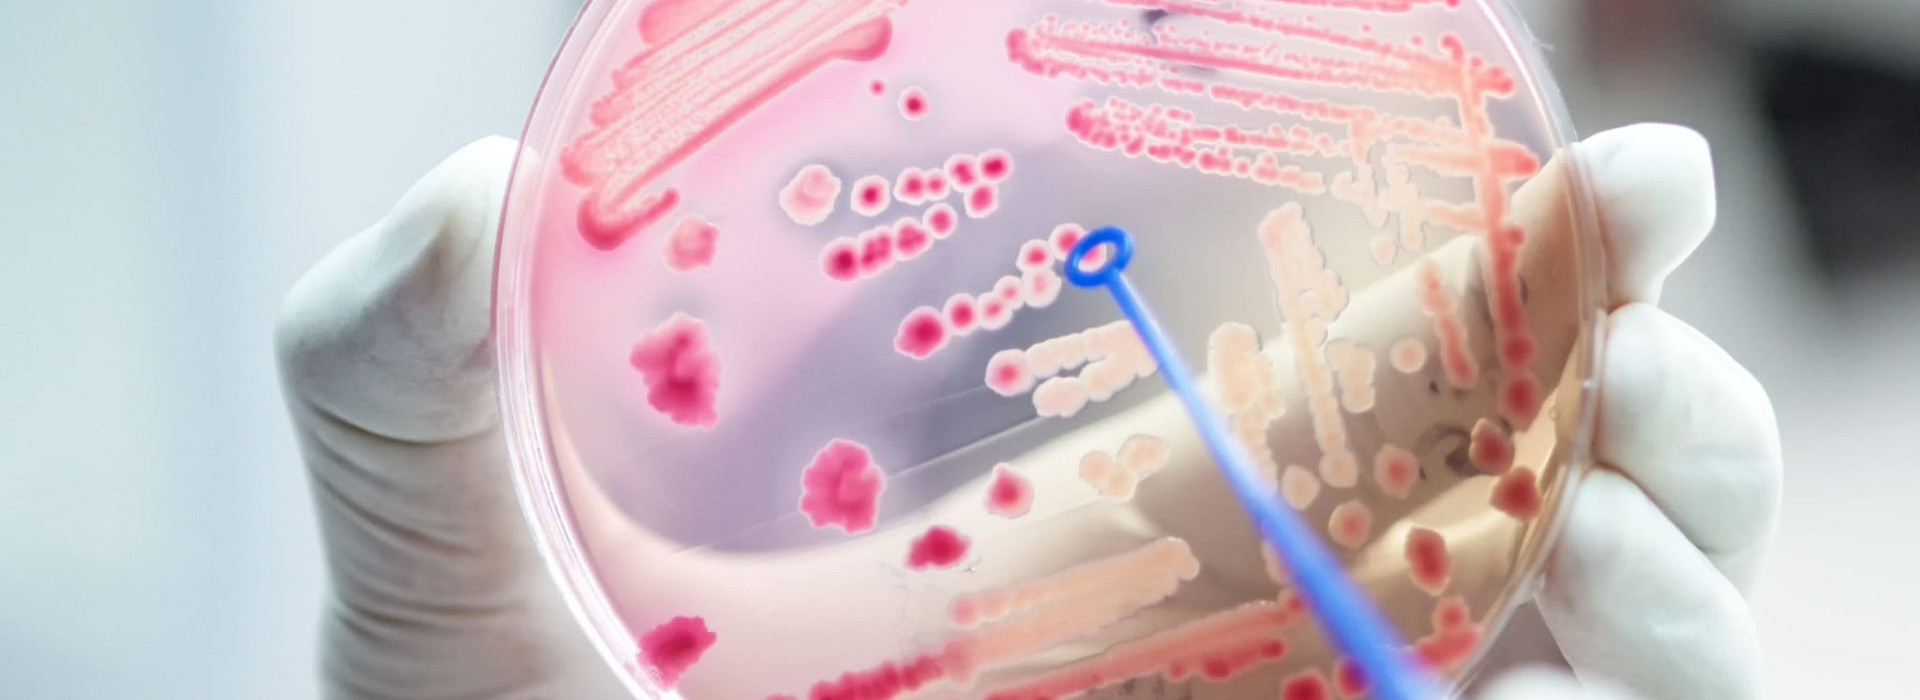

Luce: il nuovo metodo alternativo per combattere muffe e batteri
Per combattere microrganismi potenzialmente rischiosi per la vita di uomini e piante, si cerca oggi più che mai di evitare l’utilizzo di antibiotici e pesticidi. Uno dei metodi alternativi e sostenibili più efficaci e promettenti è rappresentato dalla luce che, grazie alle sue diverse lunghezze d’onda, sta raggiungendo risultati interessanti.
Vediamo qui di seguito due esempi molto interessanti.
Le potenzialità della luce blu
Sono stati i ricercatori dell’Università della Georgia a pubblicare su Applied and Environmental Microbiology un interessante studio sulle potenzialità della luce visibile blu.
La luce blu, che ha una lunghezza d’onda compresa tra 400 e 470 nanometri, può abbassare in misura significativa la carica di microrganismi presenti su superfici a contatto con alimenti senza rischi. Nello studio, in particolare, gli hanno testato l’effetto della luce blu su cinque diversi ceppi Listeria monocytogenes depositati e fatti essiccare su cinque piastrine di altrettanti materiali: acciaio inox, silicone, Pvc, polistirene e polietilene ad alta densità (Hdpe).
I ricercatori hanno sperimentato l’effetto della luce blu anche sui biofilm che la Listeria forma se lasciata proliferare per un intervallo di tempo sufficiente.
I test effettuati con esposizioni di 4, 8 e 16 ore hanno confermato che la luce blu funziona. Abbatte di mille volte la concentrazione di Listeria presente, se applicata per 16 ore, e abbassa anche la quantità di biofilm.
Enea: il robot Uvc parla italiano
I ricercatori itaiani di Enea stanno lavorando ad un progetto che prende il nome di Ormesi, un fenomeno che consiste nella reazione indotta da uno stimolo fisico, come i raggi Uvc, che ha come conseguenza un aumento nella sintesi e nella secrezione di diverse sostanze da parte della pianta, a scopo difensivo.
In base ai primi test effettuati su basilico, mele e limoni, l’esposizione ai raggi Uvc abbatte la carica microbica e consente di utilizzare il 50% in meno di fitofarmaci. In particolare, si pensa di realizzare un piccolo robot equipaggiato con lampade Uvc emittenti. Il dispositivo somministrerà la luce desiderata alle zone specifiche della pianta, in particolare quelle che sembrano maggiormente contaminate, riconosciute tramite un sensore ottico.
Fonte: https://ilfattoalimentare.it/luce-combattere-microrganismi.html